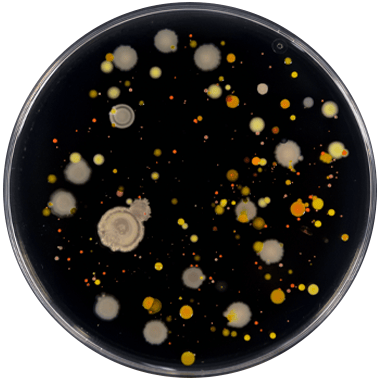

Microbiología
Microorganismos
Los microorganismos son la forma de vida más pequeña y antigua del planeta. Tienen un gran impacto en todos los ecosistemas y son responsables de modificar las condiciones ambientales para generar más vida.

Interacciones Microbianas
En los ecosistemas, los microorganismos se conectan en una compleja red de interacciones que influye en su crecimiento y desarrollo. Estas interacciones incluyen:
- Mutualismo Mutualismo: Los microorganismos establecen relaciones mutualistas con las plantas, mejorando la salud y productividad de los cultivos.
- Comensalismo Comensalismo: Algunos microorganismos muestran comensalismo, aprovechando los recursos del suelo sin dañar a las plantas u otros microorganismos. Esta relación favorece la diversidad microbiana y la salud del suelo.
- Parasitismo Parasitismo: Los microorganismos actúan como antagonistas biológicos, controlando patógenos y promoviendo la salud del suelo.

Nuestro Enfoque en AliBio
En AliBio, nuestra misión es reconectar la red de microorganismos en los ecosistemas. Lo logramos aportando un complejo diverso de microorganismos para restaurar el equilibrio ambiental.
NUESTRO PROCESO
Nuestro proceso se fundamenta en dos pilares:
La constante validación de nuestros productos actuales y el desarrollo de nuevos productos que satisfagan las necesidades cambiantes del mercado agrícola.
SELECCIONAMOS
Seleccionamos los microorganismos del laboratorio de la naturaleza que generan mayor valor en la agricultura.
Analizamos
Con la tecnología más avanzada analizamos el ADN de cada microorganismo y sus funciones para conocer completamente su potencial.
Ensamblamos
Ensamblamos nuestros consorcios microbianos de tal forma que los microorganismos se complementen entre si para generar más valor.
Testeamos
Nuestros insumos pasan por rigurosas pruebas de laboratorio y campo para ofrecer una herramienta real que mejora la productividad de sus cultivos.
FACTORES CLAVE
1
Aplicaciones
Semanales
2
Sistema
microbiano
Aplicaciones Semanales - Protocolo
Las aplicaciones semanales mantienen un crecimiento constante de microorganismos benéficos que ayudan a las plantas. En cambio, las aplicaciones mensuales, aunque comienzan con un fuerte crecimiento, muestran una disminución hacia el final del mes.

Sistema microbiano (Redundancia Funcional)
A diferencia de una cepa individual, un sistema microbiano cuenta con una amplia variedad de modos de acción, un alto nivel de supervivencia, una actividad constante y lo más importante, se crea un fenómeno llamado redundancia funcional.
Sistema microbiano

Ventajas de un sistema microbiano con diversidad de cepas y redundancia funcional:
- Amplia variedad de modos de acción
- Alto nivel de supervivencia
- Alta resistencia a cambios climáticos
- Actividad constante
Cepa inDividual

Desventajas de un producto con solo una cepa:
- Escasos modo de acción
- Baja supervivencia
- Baja resistencia a cambios climáticos
- Actividad intermitente

